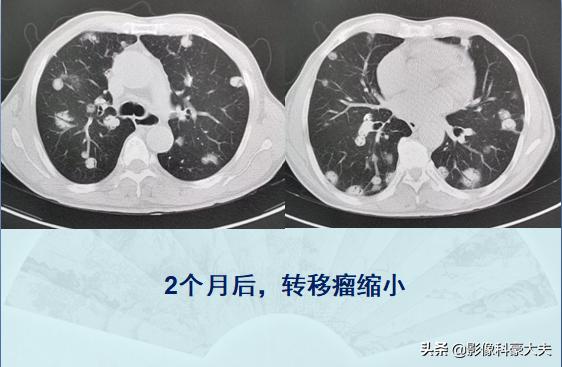
癌症晚期肺转移还能活多久,肺癌症晚期能有必要化疗吗

今天给大家看两个晚期癌症的病人,都是4个多月前确诊的,多发肺转移瘤,一个吃中药,一个打化疗,我们看一下两种治疗措施的不同。
病例1,农民,突发癌症
这是一位49岁的农村男病人,在田里干农活时突然觉得右上腹痛,放射到右边肩膀,越来越疼,赶忙撂下农具来医院挂了急诊。CT结果很残酷,癌症晚期:

他的双侧肺叶长了十余个类圆形结节,最大的1.2cm,这种形态首先要想到转移瘤。医生顺着片子往下找,在他的右上腹肝脏位置发现了原发肿瘤(左下图片箭头所示),已经超过9厘米。这是一位肝癌肺转移的病人,晚期了,因为突发上腹痛发现半天,之前没有明显症状。
很遗憾,他是一位慢性乙肝患者,如果平时重视体检,也许有机会更早一点发现。更遗憾的是,他只同意对原发肝癌的介入治疗,做了肝动脉化疗栓塞术,对肺部转移瘤选择回家吃中药。
两个月后回来复查,肝癌病灶稳定,但肺转移瘤明显增多了,呈典型的树上挂果征:

然后他依然拒绝了化疗,回家继续服用中药,又过了两个月再次回来复查,病灶继续进展,这个时候他的气色已经很差了,体重掉了差不多20斤:

中药可以治疗癌症吗?也许可以,至少可以起到调节免疫、增强体质的辅助作用,但不宜神化,不能作为唯一手段。更无语的是,他这几个月的中药,花了快4万块……
病例2,胸闷咳嗽气短,发现多发肺转移瘤
这是一位60多岁的男病人,吸烟多年,因为胸闷咳嗽气短来呼吸科检查,CT发现多发肺转移瘤,晚期了:

病理是转移性肺鳞癌(非角化型),而且很遗憾,基因检测阴性不推荐靶向治疗。之后选用化疗(吉西他滨+奈达铂),2周期后复查,转移瘤明显缩小,提示治疗有效:
病灶缩小是个好消息,于是继续治疗,又过了2个月再次复查CT,显示肿瘤进一步缩小:

这是上周刚复查的图像,老人现在没有任何不适症状,能吃能睡面色红润。化疗让他有一点点脱发,胃肠道反应为0度,就是说,他几乎没有不良反应。
晚期癌症多发转移,大部分只能追求延长寿命,难以根治
必须承认,我们还没有攻克晚期癌症,化疗、放疗、靶向治疗、免疫治疗、介入治疗等等,还只是延长寿命的手段,没有从根本上战胜癌细胞。
而一直以来,很多人对化疗畏之如虎,担心化疗反而会缩短寿命人财两空。其实以上手段都是对抗癌细胞的有效手段,合理使用都有机会创造奇迹:

这位60多岁的老太太,6年前查出肺癌伴肺门淋巴结转移,通过全身化疗和肺门区定位放疗,至今没有复发。这类长期带瘤生存的病例几乎每周都能遇到,晚期癌症病人的生存期也在逐步延长,未来可期!

我是影像科豪大夫,分享小病例,传递正能量,欢迎关注!